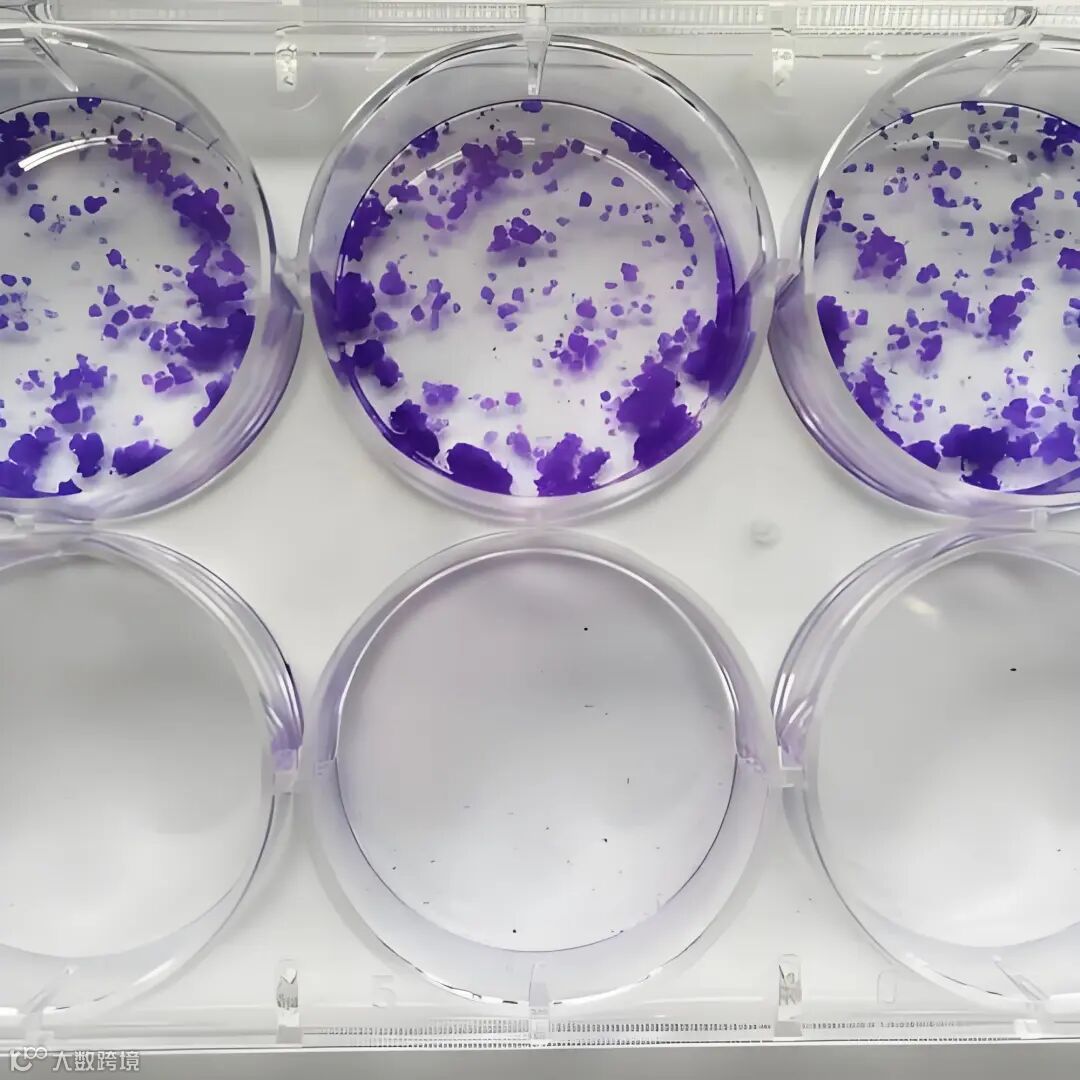
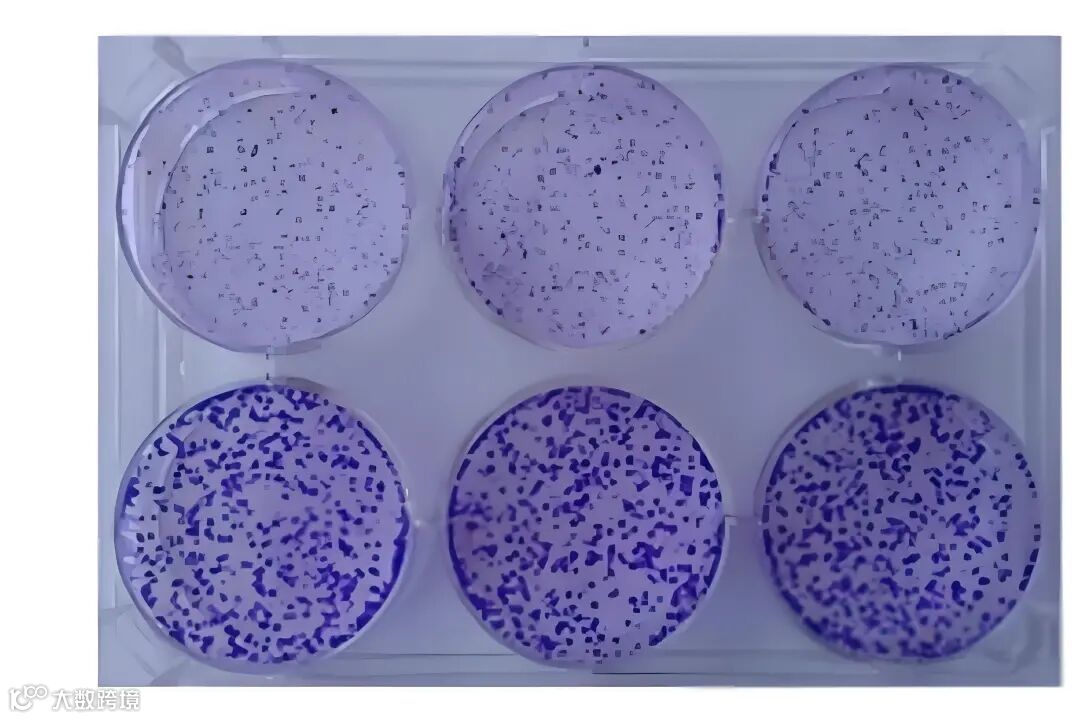

// HELLO SPRING //
克隆形成实验



克隆形成实验是一种用于研究细胞增殖能力和单个细胞增殖潜能的实验方法。通过在体外培养条件下,让单个细胞经过连续分裂繁殖形成至少6代的细胞集群(克隆或集落),并计算克隆形成率来量化分析细胞的增殖潜力。
克隆形成实验

(1)评估细胞增殖能力:通过观察和计数形成的独立克隆,了解细胞在体外环境中的增殖速率和能力。
(2)研究细胞群体依赖性:了解细胞是否需要相互合作形成克隆,有助于理解细胞群体内的相互作用和信号传导。
(3)筛选药物和治疗方案:通过比较实验前后克隆形成率,评估潜在药物或治疗方案的疗效。




①平板克隆形成实验:
适用范围:主要用于贴壁生长的细胞。
②软琼脂克隆形成实验:
适用范围:适用于贴壁和悬浮的肿瘤细胞或转化细胞系。




操作要点:
1、从对数生长期细胞开始,通过胰酶消化并计数。
2、接种细胞数量控制在400-1000个细胞/孔。
3、培养14天或直到克隆中细胞数超过50个。
4、使用4%多聚甲醛固定细胞,结晶紫染色。
5、拍照记录结果。
注意:本实验的成功关键在于细肥悬液的制奋和适度的接种密度,务必确保细胞均匀分散,防止细胞团的形成,并谨慎确保接种密度不过于密集。

(实验材料)


操作要点:
1、制备细胞悬液,调整细胞浓度至1×10³个/ml。
2、配置1.2%和0.7%的琼脂糖溶液,分别用于底层和上层琼脂。
3、接种细胞后形成双层琼脂结构,培养10-14天。
4、观察克隆数并计算形成率。
注意事项:
(1)试验中琼脂与细胞相混时,琼脂温度不宜超过40℃,以确保细肥生长不受影响;
(2)在进行细肥接种时,务必确保细胞悬液充分混匀;
(3)在培养过程中,需关注培养基的颜色,定期更换培养基,并仔细观察是否存在污染迹象:
(4)细胞铺板时密度不能太大,实验过程中速度要恍,防止局部结块。

(实验材料)
长按二维码,了解更多



END
∨ 广州晟千生物科技有限公司 ∨
联系电话
18028503457
020-62680702



